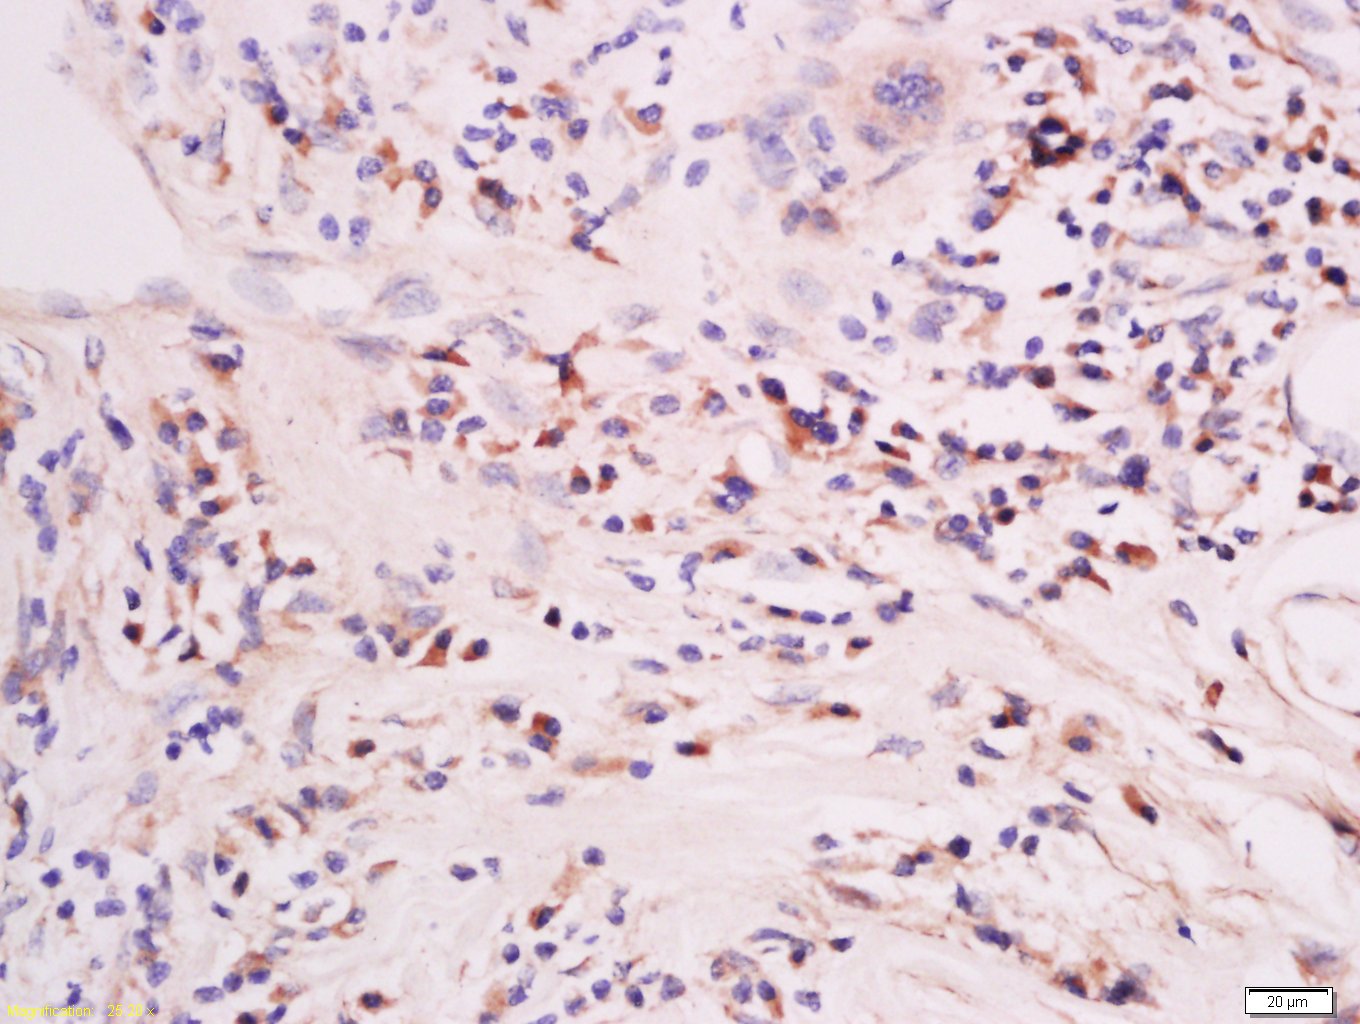
产品细节图片1

相关产品推荐更多 >

phospho-14-3-3 theta (Ser232) Rabbit pAb, BF647 conjugated(bs-13774R-BF647)-100ul
¥2980
CTDSPL Rabbit pAb, PerCP-Cy7 conjugated(bs-8241R-PerCP-Cy7)-100ul
¥2980
Glucoamylase Rabbit pAb(bs-13383R)-50ul/100ul/200ul
¥1180
IL-27beta Rabbit pAb(bs-8606R)-50ul/100ul/200ul
¥1180
CD56 Rabbit pAb, Cy5.5 conjugated(bs-0805R-Cy5.5)-100ul
¥2980
万千商家帮你免费找货
0 人在求购买到急需产品
- 详细信息
- 文献和实验
- 技术资料
- 应用范围:
产品信息以Bioss网站为准
- 规格:
50ul/100ul/200ul
| 规格: | 50ul | 产品价格: | ¥1180.0 |
|---|---|---|---|
| 规格: | 100ul | 产品价格: | ¥1980.0 |
| 规格: | 200ul | 产品价格: | ¥2800.0 |
| 产品编号 | bs-4663R |
| 英文名称 | Mst2 Rabbit pAb |
| 中文名称 | 蛋白激酶MST2抗体 |
| 英文别名 | KRS2; Mammalian STE20 like protein kinase 2; MST 2; MST2; Serine/threonine protein kinase 4; Serine/threonine protein kinase Krs 2; STE20 like kinase MST2; STK 4; STK4; STK3_HUMAN; Serine/threonine-protein kinase 3; Mammalian STE20-like protein kinase 2; MST-2; STE20-like kinase MST2; Serine/threonine-protein kinase Krs-1; Serine/threonine-protein kinase 3 36kDa subunit; MST2/N; Serine/threonine-protein kinase 3 20kDa subunit; MST2/C. |
| 产品应用 | IHC-P=1:100-500, IHC-F=1:100-500, ICC/IF=1:100-500, IF=1:100-500 Not yet tested in other applications. |
| 交叉反应 | Human, Mouse, Rat (Dog, Pig, Cow, Horse, Rabbit) |
| 抗体来源 | Rabbit |
| 免疫原 | KLH conjugated synthetic peptide derived from human Mst2 |
| 亚型 | IgG |
| 性状 | Liquid |
| 纯化方法 | affinity purified by Protein A |
| 克隆类型 | Polyclonal |
| 理论分子量 | 54 kDa |
| 浓度 | 1mg/ml |
| 储存液 | 0.01M TBS (pH7.4) with 1% BSA, 0.02% Proclin300 and 50% Glycerol. |
| 研究领域 | Cell Biology > Apoptosis > Intracellular > Kinases Signal Transduction > Protein Phosphorylation > Ser / Thr Kinases > Other Kinases |
| 亚基 | Homodimer; mediated via the coiled-coil region. Interacts with NORE1, which inhibits autoactivation. Interacts with and stabilizes SAV1. Interacts with RAF1, which prevents dimerization and phosphorylation. Interacts with RASSF1. Interacts (via SARAH domain) with isoform 1 of NEK2. Interacts with ESR1 only in the presence of SAV1. Interacts with PKB/AKT1. Forms a tripartite complex with MOBKL1B and STK38. Interacts with RASSF2 (via SARAH domain). |
| 亚细胞定位 | Cytoplasm. Nucleus. Note: The caspase cleaved form cycles between the nucleus and cytoplasm. |
| 组织特异性 | Expressed at high levels in adult kidney, skeletal and placenta tissues and at very low levels in adult heart, lung and brain tissues. |
| 翻译后修饰 | Phosphorylation at Thr-117 and Thr-384 by PKB/AKT1, leads to inhibition of its: cleavage, kinase activity, autophosphorylation at Thr-180, binding to RASSF1 and nuclear translocation, and increase in its binding to RAF1.
Proteolytically cleaved by caspase-3 during apoptosis. Proteolytic cleavage results in kinase activation and nuclear translocation of the truncated form (MST1/N). |
| 相似性 | Belongs to the protein kinase superfamily. STE Ser/Thr protein kinase family. STE20 subfamily. Contains 1 protein kinase domain. Contains 1 SARAH domain. |
| 功能 | The human serine/threonine kinase, mammalian STE20 like kinase (MST), is considerably homologous to the budding yeast kinases, SPS1 and STE20, throughout their kinase domains. When stably expressed in HeLa cells, MST highly sensitizes the cells to death receptor mediated apoptosis by accelerating caspase 3 activation. These findings suggest that MST1 and MST2 play a role in apoptosis both upstream and downstream of caspase activation. MST1 is cleaved and activated by caspases during apoptosis and is capable of inducing apoptotic morphological changes such as chromatin condensation upon overexpression. Mammalian Sterile 20 Like 2 (MST2) is most similar to the previously identified MST1 protein kinase (78% identity, 88% similarity). Northern analysis indicates that MST2 mRNA is expressed at high levels in adult kidney, skeletal and placental tissues and at very low levels in adult heart, lung, liver and brain tissues. An in vitro kinase assay indicates that MST2 can phosphorylate an exogenous substrate, as well as itself, and phospho amino acid analysis indicates that it is a serine/threonine protein kinase. |
| 保存条件 | Shipped at 4℃. Store at -20℃ for one year. Avoid repeated freeze/thaw cycles. |
| 注意事项 | This product as supplied is intended for research use only, not for use in human, therapeutic or diagnostic applications. |
| 背景资料 | This gene encodes a serine/threonine protein kinase activated by proapoptotic molecules indicating the encoded protein functions as a growth suppressor. Cleavage of the protein product by caspase removes the inhibitory C-terminal portion. The N-terminal portion is transported to the nucleus where it homodimerizes to form the active kinase which promotes the condensation of chromatin during apoptosis. Multiple transcript variants encoding different isoforms have been found for this gene. [provided by RefSeq, Jan 2012] |
| 应用 | 推荐稀释比例 |
| {IHC-P} | {1:100-500} |
| {IHC-F} | {1:100-500} |
| {ICC/IF} | {1:100-500} |
| {IF} | {1:100-500} |
Antigen retrieval: citrate buffer ( 0.01M, pH 6.0 ), Boiling bathing for 15min; Block endogenous peroxidase by 3% Hydrogen peroxide for 30min; Blocking buffer (normal goat serum,C-0005) at 37℃ for 20 min;
Incubation: Anti-Mst2 Polyclonal Antibody, Unconjugated(bs-4663R) 1:500, overnight at 4°C, followed by conjugation to the secondary antibody(SP-0023) and DAB(C-0010) staining

Antigen retrieval: citrate buffer ( 0.01M, pH 6.0 ), Boiling bathing for 15min; Block endogenous peroxidase by 3% Hydrogen peroxide for 30min; Blocking buffer (normal goat serum,C-0005) at 37℃ for 20 min;
Incubation: Anti-Mst2 Polyclonal Antibody, Unconjugated(bs-4663R) 1:500, overnight at 4°C, followed by conjugation to the secondary antibody(SP-0023) and DAB(C-0010) staining

Antigen retrieval: citrate buffer ( 0.01M, pH 6.0 ), Boiling bathing for 15min; Block endogenous peroxidase by 3% Hydrogen peroxide for 30min; Blocking buffer (normal goat serum,C-0005) at 37℃ for 20 min;
Incubation: Anti-Mst2 Polyclonal Antibody, Unconjugated(bs-4663R) 1:200, overnight at 4°C, followed by conjugation to the secondary antibody(SP-0023) and DAB(C-0010) staining




风险提示:丁香通仅作为第三方平台,为商家信息发布提供平台空间。用户咨询产品时请注意保护个人信息及财产安全,合理判断,谨慎选购商品,商家和用户对交易行为负责。对于医疗器械类产品,请先查证核实企业经营资质和医疗器械产品注册证情况。
文献和实验[IF={{ 5.5 }}] {Li Lin. et al. GPR137 inactivates Hippo signaling to promote gastric cancer cell malignancy. BIOL DIRECT. 2024 Dec;19(1):1-16} {WB} {Human}
= NAL), appears to form upon oxidative cyclization of the nonfluorescent 2:1 lysine-HNE Michael adduct-Schiff base cross-link (Scheme 1). Polyclonal antibody (PAb) to the NAL-HNE fluorophore was raised in rabbit and found to be highly specific
GE Healthcare Benzamidine Sepharose™ 6B is p-aminobenzamidine covalently attached to Sepharose 6B by the epoxy coupling method. p-Aminobenzamidine (PAB), is a synthetic inhibitor of trypsin-like serine protease. Trypsin and trypsin
Nucleic Acid Programmable Protein Arrays: Versatile Tools for Array‐Based Functional Protein Studies
.g., Sigma) 50 mg/ml bis‐sulfosuccinimdylsuberate (BS3 ;Pierce, cat. no. PI 21580) in dimethylsulfoxide (DMSO) 5 mg/ml
技术资料暂无技术资料 索取技术资料






